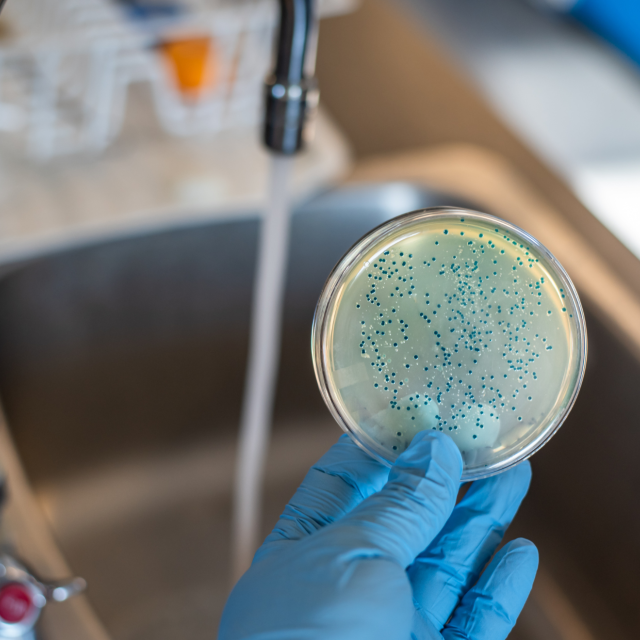

W oparciu o badania z dnia 20 listopada i wydany komunikat Państwowego Powiatowego Inspektora Sanitarnego informujemy, że w wodociągu grupowym „Łacha” nie stwierdzono już obecności bakterii grupy coli. Stwierdzono jeszcze ponadnormatywną ilość mikroorganizmów w 1 ml wody w temperaturze 22st. C.
W związku z tym w oparciu o decyzję Państwowego Powiatowego Inspektora Sanitarnego w Legionowie informujemy, że woda z wodociągu gminnego administrowanego przez MGZW w Serocku, zaopatrująca odbiorców w miejscowościach: Łacha, Gąsiorowo, Nowa Wieś, Kania Polska, Kania Nowa i Cupel jest w dalszym ciągu
WARUNKOWO PRZYDATNA DO SPOŻYCIA
- Wodę z wodociągu zbiorowego zaopatrzenia można spożywać wyłącznie po jej wcześniejszym przegotowaniu.
- Woda bez przegotowania może być stosowana do codziennego mycia, prania, prac porządkowych i spłukiwania toalet.
- Woda poddawana jest w dalszym ciągu dezynfekcji i może wykazywać zapach chloru.
Pobór próbek wody zaplanowano na 26 listopada. Wyniki będą znane 1 grudnia, kiedy zostanie wydany kolejny komunikat.
!!! Wodę przeznaczoną do spożycia i przygotowania posiłków dla niemowląt i dzieci do 2 lat, oraz osób ze znaczną obniżoną odpornością należy gotować przez minimum 2 minuty a następnie bez gwałtownego schładzania pozostawić do ostudzenia. Woda bez przegotowania może być stosowana do codziennego mycia, prania itp.
Miejsko-Gminny Zakład Wodociągowy
w Serocku
 Aktualności
Aktualności Wydarzenia
Wydarzenia O Serocku
O Serocku Kultura
Kultura Serockie Inwestycje Samorządowe
Serockie Inwestycje Samorządowe Dla Mieszkańca
Dla Mieszkańca Urząd Miasta i Gminy
Urząd Miasta i Gminy Oświata
Oświata Zdrowie
Zdrowie Pomoc społeczna
Pomoc społeczna Wodociągi
Wodociągi Sprawy komunalne
Sprawy komunalne Inwestycje gminne
Inwestycje gminne Fundusze zewnętrzne
Fundusze zewnętrzne